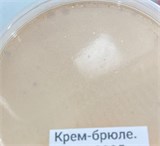
Крафтовое авторское натуральное Мороженое, в ассортименте 41670 - фото 14048
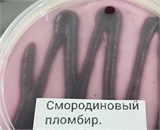
Крафтовое авторское натуральное Мороженое, в ассортименте 41670 - фото 14055

Крафтовое авторское натуральное Мороженое, в ассортименте
199
₽
Артикул:
41670
Ед. измерения:
шт.
Под заказ
Количество:
Доступно
Доставка в
Голицыно
Похожие товары

}})
}})
}})
}})
}})
}})
}})
}})
}})
